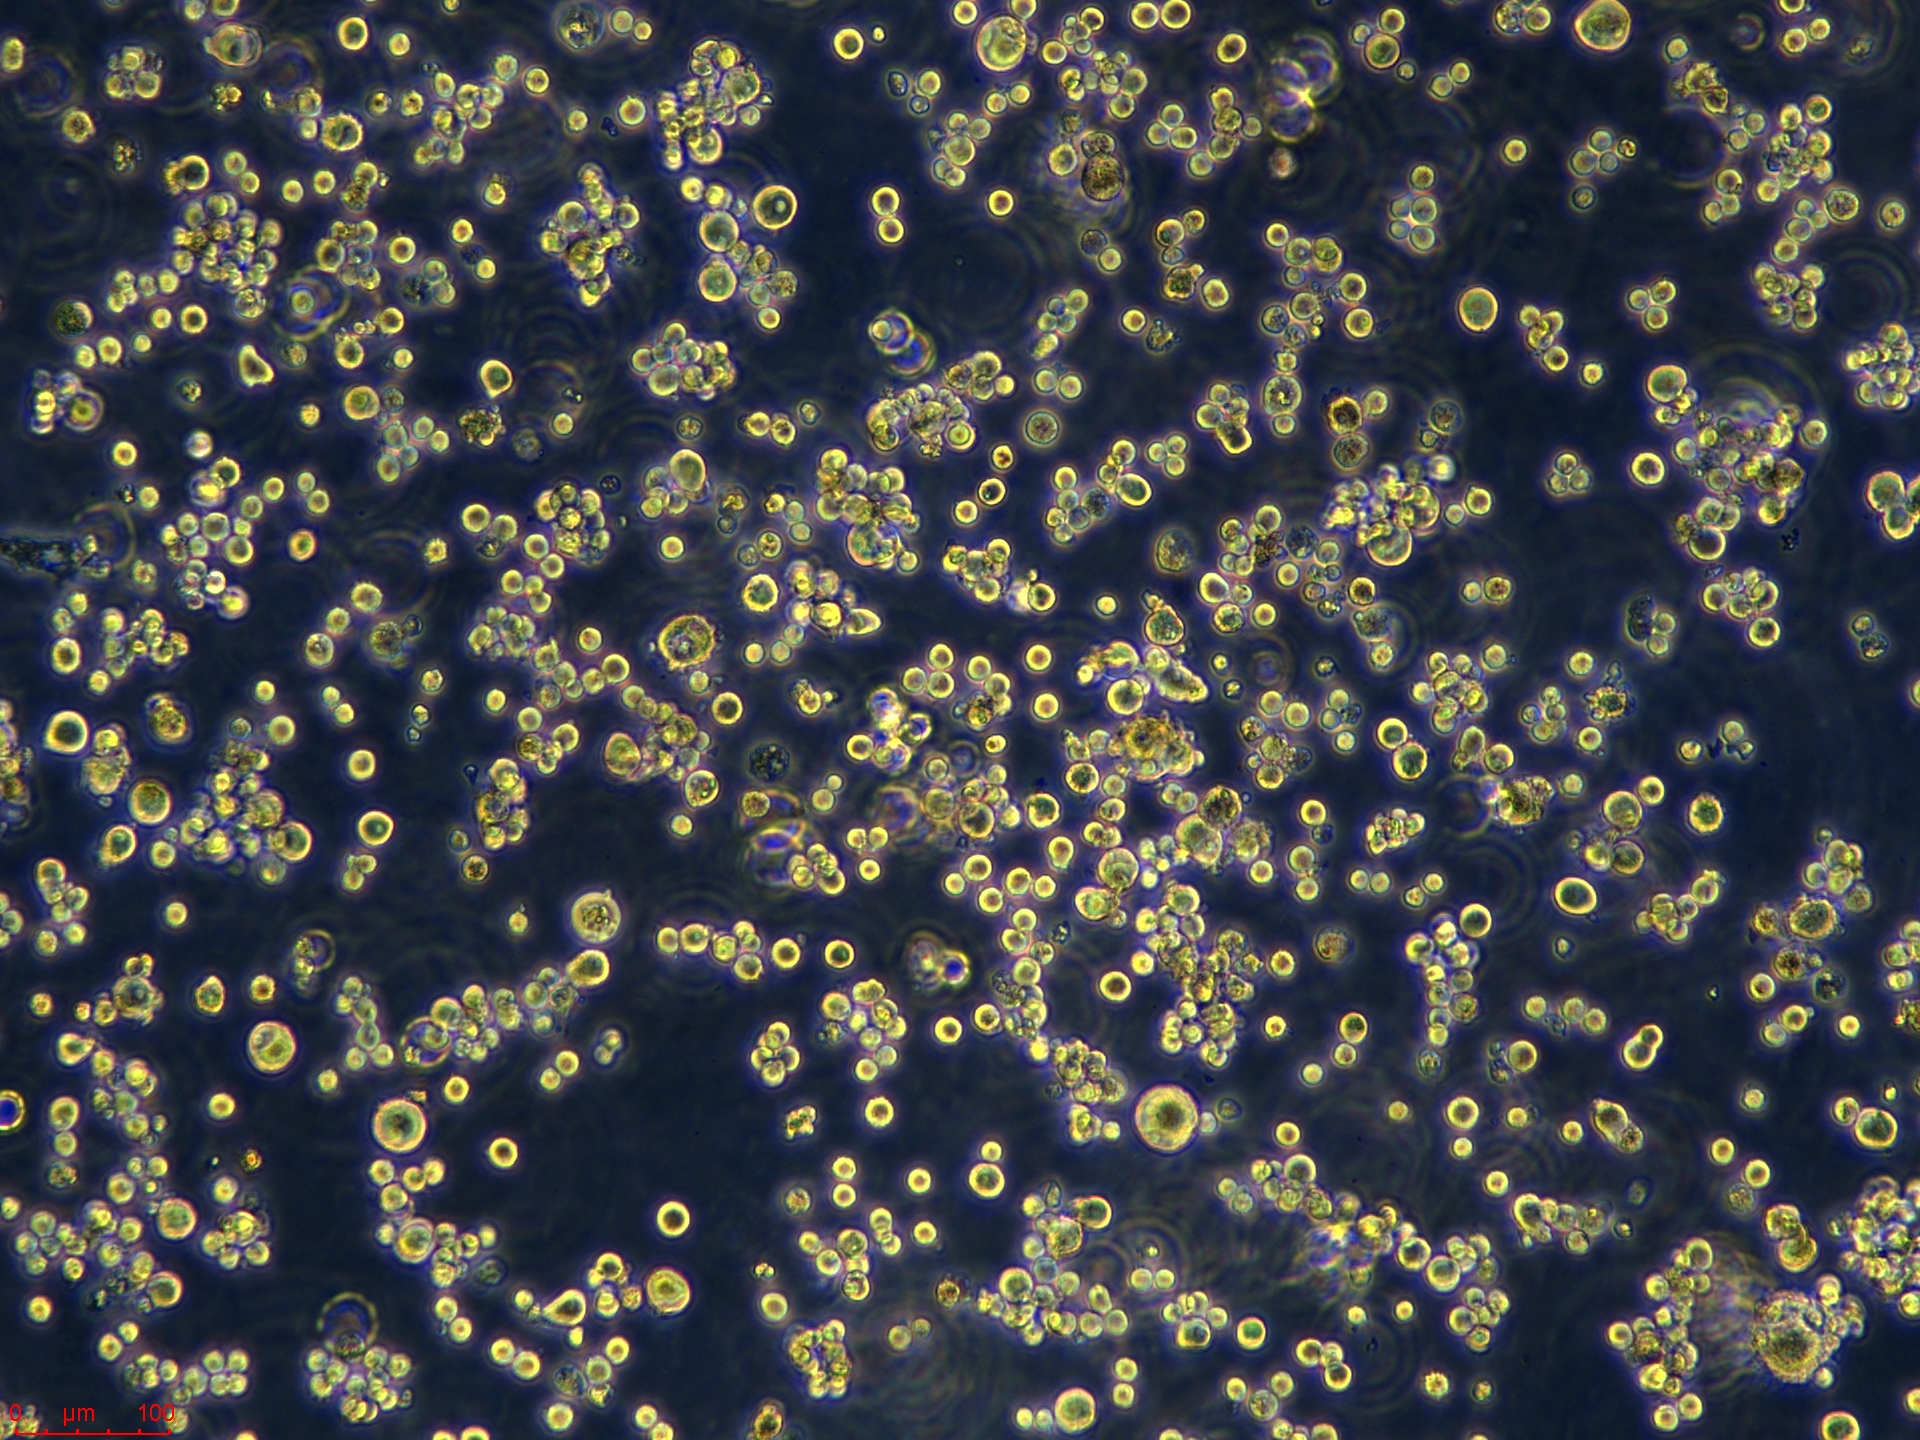
Project_WALKER-LLC-WRC256_ch00.jpg

相关产品推荐更多 >
万千商家帮你免费找货
0 人在求购买到急需产品
- 详细信息
- 文献和实验
- 技术资料
- 英文名:
Walker/LLC-WRC 256
- 库存:
99
- 细胞类型:
科研细胞
- 品系:
细胞株
- 组织来源:
乳腺(Mammary gland)
- 物种来源:
小鼠(Mus musculus)
- 细胞形态:
表皮细胞(Epithelial)
- 运输方式:
常温或干冰冻存发货 空运、快递
- 生长状态:
贴壁生长(Adherent)
- 规格:
T25
规格属性介绍
| 规格 | T25 |
| 货号 | CTCC-400-0386 |
| 种属 | 大鼠(Rattus norvegicus) |
| 组织来源 | 乳腺(Mammary gland) |
| 疾病 | 未知(Unknown) |
| 年龄 | 未知(Unknown) |
| 培养体系 | 该细胞系培养所用基本培养基为 Medium 199,配置完全培养基时需加入 5% Horse Serum,1% Anti-Anti。 |
| 细胞形态 | 表皮细胞(Epithelial) |
| 生长特性 | 贴壁生长(Adherent) |
细胞图片

风险提示:丁香通仅作为第三方平台,为商家信息发布提供平台空间。用户咨询产品时请注意保护个人信息及财产安全,合理判断,谨慎选购商品,商家和用户对交易行为负责。对于医疗器械类产品,请先查证核实企业经营资质和医疗器械产品注册证情况。
文献和实验免疫组化试剂 >>>SP 试剂盒 货号
in controlling myosin activity in Walker carcinosarcoma cells and show that an appropriate level of RhoA, Rac, and Rho-kinase activity is required to regulate cell polarity and migration.Low expression of MRP1/GS-X pump ATPase in lymphocytes of Walker 256 tumour
PNAS | 空间分辨代谢组学方法揭示“下游代谢物与上游代谢酶关联”的癌症相关代谢变化
的细胞保护剂来改善癌症治疗。根据一些研究者的说法,基于组胺的治疗能促进癌细胞中 DNA 损伤、凋亡和衰老并可以显著增加患癌动物的存活率。在本研究中,组氨酸和组胺呈现完全相反的空间分布。根据 256 例食管癌组织样本的成像数据,组氨酸在癌组织中显著上调而组胺显著下调。组胺与组氨酸的离子强度差异如图3B7所示。通过计算组胺与组氨酸的离子强度比,对HDC介导的组氨酸脱羧反应进行了研究(图3B6),发现肿瘤组织的脱羧率相对于肌肉和上皮组织较弱。和基于强度比的质谱成像预测的一致,肿瘤组织的 HDC 表达
技术资料暂无技术资料 索取技术资料










